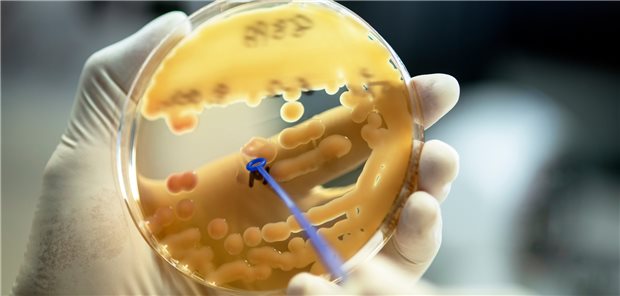
Klebsiella pneumoniae: Isolate des Bakteriums werden seit dem Frühjahr 2022 stark vermehrt in Proben aus deutschen Kliniken nachgewiesen.

Themenseite MRE
Themenseite - MRE
Projekte zu Seltene Erkrankungen, Impfen Antibiotikaverordnung
Innovationsausschuss hält drei Studien für transferwürdig
02.04.2024
|
Chlorhexidin und Iodophor
Drei Maßnahmen gegen multiresistente Erreger in Kliniken und Heimen
09.06.2023
|
Multiresistente Keime
Fast jeder fünfte Säugling mit Sepsis und positiver Blutkultur starb
06.06.2023
|
Unnötige PPI-Therapien vermeiden!
PPI-Therapie: Einladung für multiresistente Enterobakterien
02.02.2023
|
Nationales Referenzzentrum (NRZ)
Mehr multiresistente Keime in deutschen Krankenhäusern seit Beginn des Ukrainekriegs
Meinung